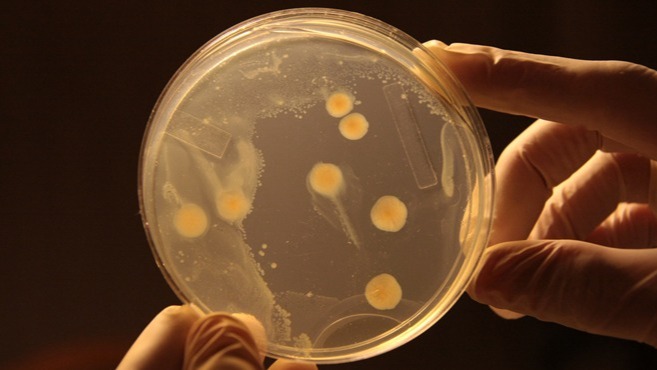
Bacteria, health , inflammatory , disorders, gut microbiome,  E.coli

When Strains Of E.coli Play Rock-Paper-Scissors, It Is Not The Strongest That Survives.
Bacteria is all around the USA not simply in loos or room counters, however additionally within our bodies, as well as in tumors, wherever microbiota typically flourish. These 'small ecologies' will hold the key to antineoplastic therapies and learning a lot regarding them will facilitate the develo
Interested in the attainable reasons for this outcome.
Bacteria is all around the USA not simply in loos or room counters, however additionally within our bodies, as well as in tumors, wherever microbiota typically flourish. These "small ecologies" will hold the key to antineoplastic therapies and learning a lot regarding them will facilitate the development of new life-saving treatments.
What happens once completely different strains of microorganism area unit gift within the same system? Do they co-exist? Do the strongest survive? in an exceedingly microbic game of rock-paper-scissors, researchers at the University of Golden State San Diego's BioCircuits Institute uncovered a shocking answer.
Their findings, titled "Survival of the lowest in non-transitive uneven interactions among strains of E. coli," appeared in an exceedingly recent edition of Nature Communications. The analysis team consisted of faculty members of applied science and biological science Jeff Hasty; Michael Liao dynasty and Arianna Miano, each applied science graduate student; and Chloe Nguyen, an applied science collegian.
They designed 3 strains of E. coli (Escherichia coli) so every strain made a poisonous substance that might kill one different strain, similar to a game of rock-paper-scissors.
When asked however the experiment passed off, Hasty commented, "In artificial biology, complicated factor circuits area unit generally characterized in microorganism that area unit growing in well-mixed liquid cultures.
However, several applications involve cells that area unit restricted to grow on a surface. we tend to needed to know the behavior of little designed ecologies once the interacting species area unit growing in AN surroundings that's nearer to however microorganism area unit probably to colonize the chassis."
The researchers mixed the 3 populations along and allow them to grow on a dish for many weeks. once they checked back they detected that, across multiple experiments, the constant population would take over the complete surface -- and it wasn't the strongest (the strain with the foremost potent toxin). interested in the attainable reasons for this outcome, they devised AN experiment to unveil the hidden dynamics at play.
There were 2 hypotheses: either the medium population (called "the enemy of the strongest" because the strain that the most effective would attack) would win or the weakest people would win. Their experiment showed that, astonishingly, the second hypothesis was true: the weakest population systematically took over the plate.
Going backward to the rock-paper-scissor analogy, if we tend to assume the "rock" strain of E.coli has the strongest poisonous substance, it'll quickly kill the "scissor" strain. Since the cut strain was the sole one able to kill the "paper" strain, the paper strain currently has no enemies. It's liberal to eat away at the rock strain slowly over an amount of your time, whereas the rock strain is powerless to defend itself.
To make sense of the mechanism that slows this development, the researchers additionally developed a mathematical model that might simulate fights between the 3 populations by ranging from a good sort of patterns and densities.
The model was able to show however the microorganism behaved in multiple situations with common spatial patterns like stripes, isolated clusters, and homocentric circles. only the strains were at first distributed within the pattern of homocentric rings with the strongest within the middle, was it attainable for the strongest strain to require over the plate.
It is calculable microbes amount human cells ten to one within the chassis and several other diseases are attributed to imbalances at intervals varied microbiomes. Imbalances at intervals in the gut microbiome are coupled to many metabolic and inflammatory disorders, cancer, and even depression.
the flexibility to engineer balanced ecosystems that {may} be for long periods of your time may modify exciting new potentialities for artificial biologists and new tending treatments. The analysis that Hasty's cluster is conducting could facilitate lay the inspiration to 1 day engineer healthy artificial microbiomes that may be wont to deliver active compounds to treat varied metabolic disorders or diseases and tumors.
Vice-Chancellor for analysis Sandra Brown same, "Bringing along biological science and bioengineering has allowed discovery with the potential to enhance the health of individuals around the world. this can be a discovery that will ne'er have occurred if they weren't operating collaboratively. this can be another testament to the ability of UC San Diego's multidisciplinary analysis."
Disclaimer: The opinions expressed within this article are the personal opinions of the author. The facts and opinions appearing in the article do not reflect the views of 25hrNews and 25hrNews does not assume any responsibility or liability for the same.

(+91) 8081113111
(+91) 8081113111 pr@25hrnews.com
pr@25hrnews.com
